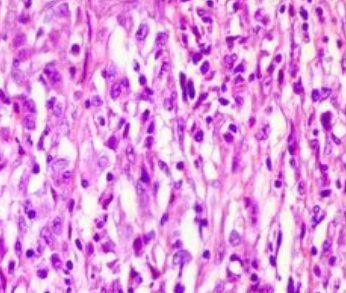
微信截图_20220427134126.png

FITC-WFA,WFL;荧光素标记紫藤凝集素(WFA,WFL),Fluorescein labeled Wisteria Floribunda Lectin (WFA, WFL)
西安市pg电子娱乐游戏app
生物学技术**制造一类型的凝集素;直接展示一些荧光标志突显偶联的凝集素。展示罗丹明、CY3、CY5、FITC、生物学技术素Biotin、琼脂糖Agarose、DyLight 488、DyLight 594、DyLight 649、Texas Red标志一些凝集素。凝集素(Lectin)包含另一个项从多种苔藓观赏仿真植物,无脊椎骨家禽和高教家禽中提炼的糖球核核蛋白质或运用糖的球核核蛋白质,因为有能凝集红血球(含血型物料),故名凝集素。选用的为苔藓观赏仿真植物凝集素(Phytoagglutin,PNA),一般是而使被领取的苔藓观赏仿真植物重命名,如刀豆素A(Conconvalina,ConA)、麦胚素(Wheat germ agglutinin,WGA)、红薯凝集素(Peanut agglutinin,PNA)和黄豆凝集素(Soybean agglutinin,SBA)等,凝集素是患者的总称。凝集素能够 用作另一个项电极来探究生殖细胞上其他的糖基。另一个等方面,凝集素更具多价运用本事,能与FITC荧光素、生物学制品素、酶、悬浊液金和铁球核核蛋白质等示踪物运用,若想在光镜与/或电镜关卡提示 其运用连接。一般是采用了荧光素、辣根过阳极金属氧化物酶、铁球核核蛋白质、悬浊液金、Cyanine或生物学制品素等对其进行符号。凝集素就是一种碳水无机化合物联系球蛋白,的存在于绿植的根,嫩芽,花叶子,種子和茎中。凝集素建在血细胞质和血细胞核中。紫藤的凝集素的采用:利用免疫抗体荧光探析小鼠人的大脑中的会阴感觉神经元网和菜鸟蛋清网经过细孔板分析分析变更到高斯荧光素酶(GLuc)底物的N-乙酰半乳糖胺(GalNAc)的量探究其对会阴膜网的融合用途包装盒产品规格:1mg,5mg打包图片尺寸系统设计核氨基酸分量血生化/生理变化做用凝集素与多糖、糖脂和糖蛋清的聚糖包括高吸引力配合,进行绿植的减伤。WFA没有血型特男人的,但对N-乙酰基-D- 半乳糖胺具备着亲和。定量分析就说明凝集可溶性以 μg/ml显示,同时是针对1mg/ml聚磷酸盐储存淡盐水(pH 6.8)的国产摇匀液参与测试的。该可溶性是在25℃因素下温育1小后凝集2%人血型A红肿瘤细胞浮窗液的*低密度。

pg电子娱乐游戏app
微信公众号
官方微信